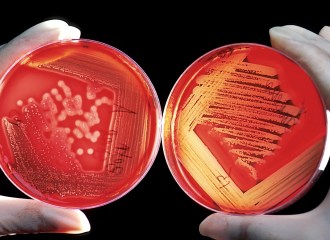

S’approfundar en linguas e culturas da tut il mund? Scuvrir epocas istoricas e biografias captivantas? Chapir connexs politics, economics e socials? Emprender d’enconuscher terras estras u refrestgentar la savida davart la flora e fauna? Tut quai e bler dapli porschan ils texts tematics.
Tar ils texts tematics sa tracti da cudeschs stampads, da contribuziuns ch’èn cumparidas en periodicas, da rimnadas d’artitgels da gasetta u da cudeschs da Vichipedia che sa laschan leger en furma dad e-book u empustar sco book-on-demand.
Ultimas contribuziuns
 Il Son Gottard e ses ospizis
Il Son Gottard e ses ospizis
Il Gottard ha giugà ina rolla essenziala en il svilup da la schientscha naziunala svizra, e quai dal temp da fundaziun fin la defensiun spiertala dal 20avel tschientaner. Las relaziuns, politicas, da traffic e socialas en fluctuaziun sa manifesteschan er en ils ospizis sin il pass.
 Timeline. La Svizra en transfurmaziun
Timeline. La Svizra en transfurmaziun
Temp da guerra ed onns da boom, dumondas socialas ed ecologicas, la sfida da la globalisaziun… Il cudesch ‹La Svizra en transfurmaziun› preschenta l’istorgia dal pajais dals onns 1930 fin l’entschatta dal 21avel tschientaner – a moda cumpacta e tuttina en ina varietad tematica surprendenta.
 Nums populars d’utschels
Nums populars d’utschels
Il chant caracteristic da la quacra sa cumpona da trais tuns successivs cun in accent ferm sin l’emprim e sin il terz tun. La fantasia creativa rumantscha fa londeror in ‹fúf-fadútg›, in ‹sách-badách› ed in ‹quít-squilát›, e gia avain nus trais bellezza nums per la pitschna giaglina selvadia…